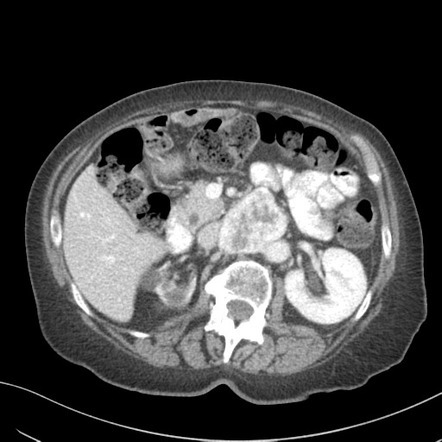

zona glomerulosa produces:
aldosterone
zona fasciculata produces:
glucocorticoids
zona reticularis produces
produces adrogens
adrenal cortex layers superficial to deep
zona glomerulosa, zona fasciculata, zona reticularis
cushing disease
excess cortisol production by excessive PITUITARY ACTH
hypertension and hypokalemia
Conn syndrome
does ACC produce hormones
yes - it arises from the cortex and usually causes an increase in all cortical adrenal hormones and precursors
Waterhouse-Friderichsen syndrome
post-hemorrhagic adrenal failure secondary to Neisseria meningitidis
autoimmune destruction of the adrenal glands
Addison disease
at what HU can an adrenal adenoma be diagnosed?
<10 HU
what % of adenomas are lipid rich?
80%
what is a collision tumor in the adrenal gland?
a metastasis into an adrenal gland with a pre-existing adenoma
for adrenal washout protocol, what is diagnostic of an adrenal adenoma? (absolute washout)
> 60% absolute washout

for the adrenal washout protocl what % washout diagnostic for an adrenal adenoma? (relative washout)
> 40% relative washout
relative washout means no noncontrast due to radiation exposure


adrenal myelolipoma

presacral myelolipoma
most common type of adrenal cyst
endothelial
endothelial (45%) > pseduocyst (trauma) (40%) > epithelial (10%)

pheochromocytoma
pheochromocytomas arise from what cell type
chromaffin cells
Syndromes associated with pheochromocytomas
paraganglioma at the organ of zuckerkandl


paraganglioma at the organ of Zuckerkandl

faints when he pees

post-mictruition syncope = bladder paraganglioma
syncope when pees

MIBG-123 uptake at the bladder wall in a bladder paraganglioma
MIBG does not have renal or bladder uptake, so abnormal activity there = paraganglioma